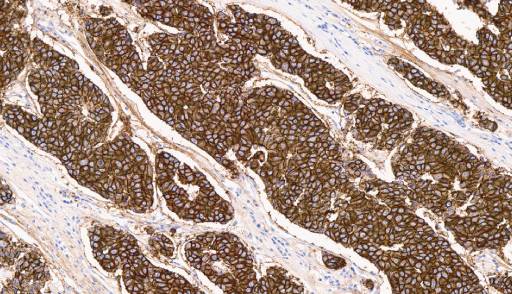
IHC webinar

Biopharma solutions resources
Explore our library of white papers, webinars, and expert resources. New content is added regularly to keep you informed and ahead.

Multi-modality testing of EGFR: A comprehensive approach to clinical trial testing for improved therapeutic outcomes

Overcoming the challenges of spatial biology with an innovative AI-driven hyperplexed solution - Paletrra™
On demand webinars

Decoding the tumor microenvironment with Paletrra™: Revolutionizing biomarker discovery in clinical trials

Comprehensive characterization of the tumor microenvironment using a novel fully validated tissue biomarker discovery assay